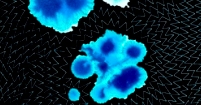

LEAF: Leaves like many of nature’s designs are always one of a kind. The differences and the similarities in the veining supply much variety and new challenges for execution. The vivid colors of the many tropical plants that surround my home are a great inspiration.

TREE: I use the classical technique of reverse applique to execute decidedly contemporary graphic depictions of natural forms and phenomena. I like the complexity of nature’s intersections which outline shapes that repeat irregularly throughout these compositions. They have a chaotic patterning reminding me of an unknown language which somehow transmits a sense of serenity

FINGERPRINT: Now numbering more than 50 quilts, this series continues to grow and transform. These are large abstract maps of individuality that are uniquely one of a kind and stand equally well alone or together.

NARRATIVE: Stitching multiple layers of cloth together with several techniques combines the traditional with the new. Fine mixed media painting along with both hand and machine stitching to produces universally appealing wall hangings. These are stitched art works that contain mixtures of obvious metaphors, ancient references and modern icons.